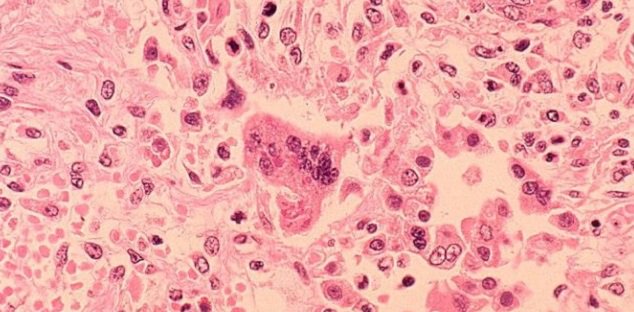
Case of measles confirmed in Scarborough 
durhamradionews.com/archives/117461

Otter Greenhouses
@ottergreenhouse
We are a large, family owned greenhouse located in Port Perry, Ontario serving both the retail and wholesale markets.
ID: 1311534164
http://www.ottergreenhouses.com 28-03-2013 19:31:08
423 Tweet
333 Takipçi
405 Takip Edilen

And they’re off!! More than 3,000 #plants, #trees and #shrubs at Otter Greenhouses are being loaded onto a transport truck heading to Exhibition Place for Canada Blooms! See the beautiful garden displays at the show while visiting the #NationalHomeShow presented by @REMAXca March 8-17.














The missing male has ties to Oshawa, if you see him please contact your local police service. Kingston Police